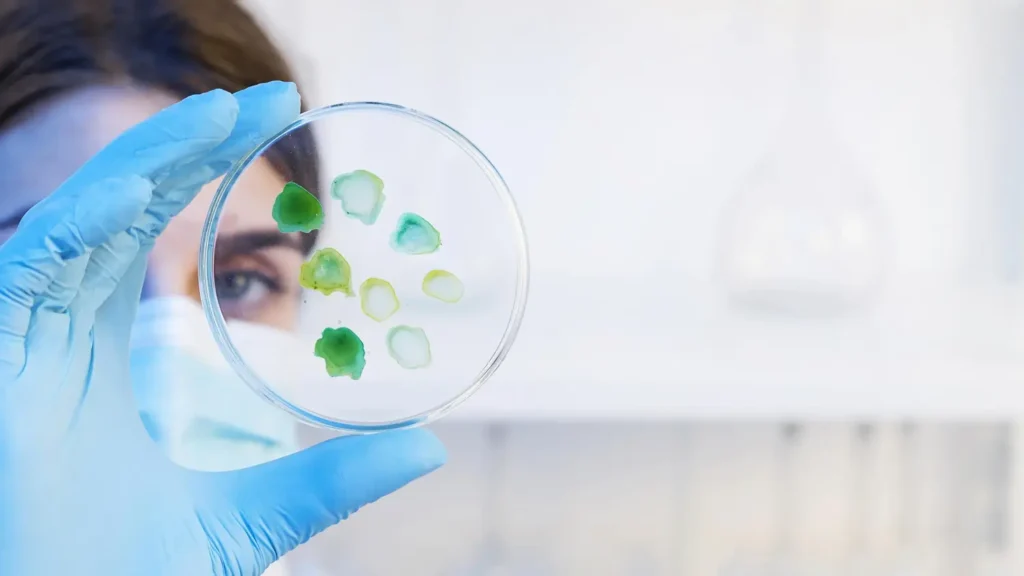

Profesionales en biología, bioquímica, biotecnología, Farmacia, química, medio ambiente, y áreas afines que deseen orientar su futuro hacia la investigación.
Al concluir el máster, los participantes serán galardonados con una titulación oficial otorgada por ISEIE Innovation School. Esta titulación se encuentra respaldada por una certificación que equivale a 60 créditos ECTS (European Credit Transfer and Accumulation System) y representa un total de 1500 horas de dedicación al estudio.
Esta titulación de ISEIE no solo enriquecerá su imagen y credibilidad ante potenciales clientes, sino que reforzará significativamente su perfil profesional en el ámbito laboral. Al presentar esta certificación, podrá demostrar de manera concreta y verificable su nivel de conocimiento y competencia en el área temática del programa.
Esto resultará en un aumento de su empleabilidad, al hacerle destacar entre otros candidatos y resaltar su compromiso con la mejora continua y el desarrollo profesional.